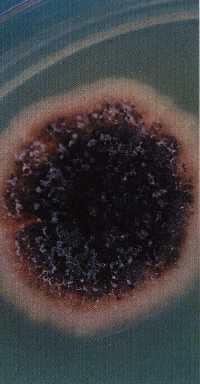
炭そ病菌の菌叢（培養１２日目）

炭そ病
病害(かび)
症状の特徴
1)葉、葉柄、つるおよび果実などあらゆる部位で発生をみる。葉では径3〜20mm程度の縁が不定形の円形の病斑が生じる。病斑の縁は褐色を呈し、中央部は退色して破れやすくなる(写真1)。
2)葉柄では淡褐色の紡すい形のくぼんだ病斑が生じ、縦に小さな亀裂が入ることもある(写真2)。
3)果実では、最初油浸状の小さな斑点が生じ、やがて拡大し、くぼみ、鮭肉色の粘着物が形成され、亀裂が入る(写真3,4)。病斑部に小さな黒点が形成されることもある。
4)罹病部位から培地で炭そ病菌(Co11etotrichum属)を分離すると、はじめに鮭肉色の分生子層が現れ、やがてコロニーの中央から黒変する(写真5)。分生子層上に剛毛(写真6)や分生子が生じる。
発生しやすい条件
1)気温22〜24℃で降雨が続いたときに発病しやすい。
2)連作および排水不良圃場で発生が多い。
3)窒素肥料の多施用で発病が助長される。
紛らわしい障害(関連の障害参照)
・べと病、灰色かび病および斑点細菌病の葉部における病徴。